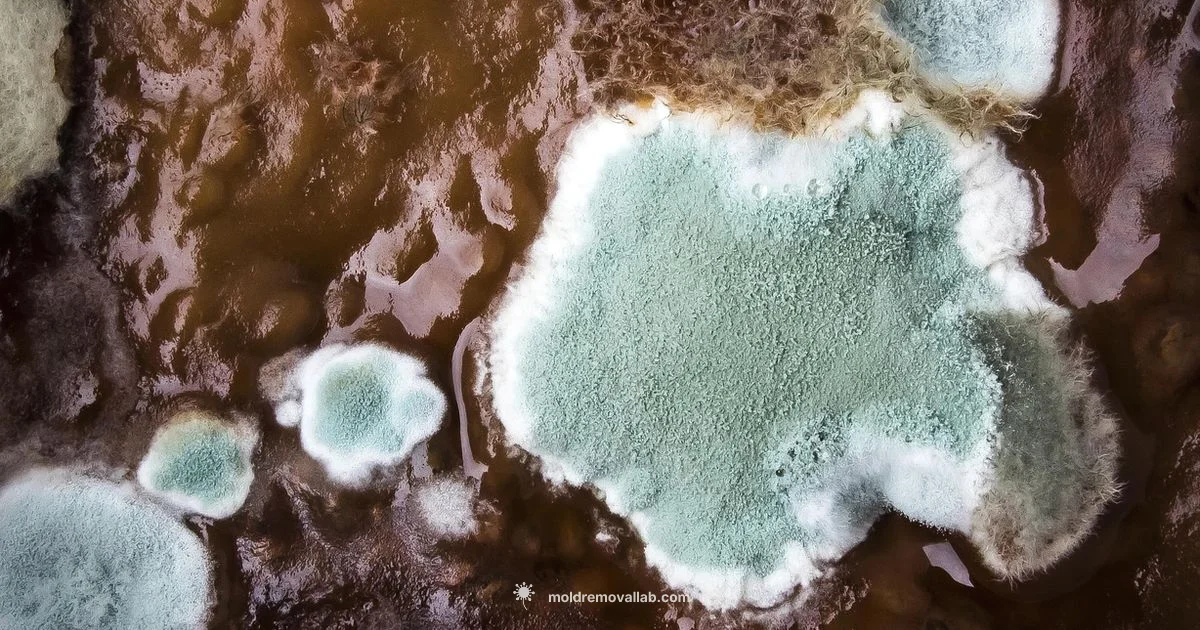
Mold Spores Overview - Mold Removal Lab

What Are Mold Spores
Learn what mold spores are, how they affect indoor air quality, where they come from, and practical steps to manage and safely remove mold in homes.
Mold spores are microscopic reproductive units produced by mold fungi. They travel through the air and can seed new colonies when they land on damp surfaces.
What mold spores are and why they matter
To answer what are mold spores, mold spores are microscopic reproductive units produced by mold fungi. They travel through the air, land on surfaces, and can start new colonies when moisture is present. According to Mold Removal Lab, mold spores are a common feature of indoor environments, but their presence at elevated levels signals persistent dampness and potential health risks. Understanding what mold spores are helps homeowners recognize why moisture control is the foundation of mold prevention and why preventing mold growth reduces airborne spores.
Spore concentrations vary daily and by room, depending on humidity, temperature, and airflow. Some spores are allergenic or irritating to sensitive people, while certain species can produce odors or cause cosmetic damage to building materials. Because spores constantly circulate in most homes, the goal is not total elimination but management of moisture and regular cleaning to keep airborne spores at levels that are manageable for occupants.
How spores travel through your home
Mold spores are carried by air currents generated by HVAC systems, fans, open doors, and even walking, clothes, and pets. They can enter from outside or be released from existing mold growth inside. Common hotspots include bathrooms, kitchens with leaks, basements, and crawl spaces where moisture lingers. Proper ventilation and moisture control reduce the likelihood that spores will settle and form new colonies.
Regular cleaning helps remove settled spores from surfaces, while filter systems with well maintained pleated filters can capture many airborne particles. Keep in mind that spores can cling to fabrics and dust, so comprehensive cleaning should include soft furnishings and HVAC ducts where possible.
Health impacts and susceptible groups
In most people mold spores cause mild symptoms like eye irritation, sneezing, or a runny nose when exposure is limited. For individuals with mold allergies, asthma, or weakened immune systems, exposure can trigger more significant reactions, including coughing or breathing difficulties. Young children and the elderly may be more sensitive to airborne spores. The Mold Removal Lab Team notes that persistent exposure in damp environments can worsen respiratory symptoms, so controlling moisture is a central prevention strategy.
Testing and evaluating mold spore contamination
Testing for mold spores is not routinely required in a healthy home, but it can help guide remediation when moisture is ongoing or visible mold is present. Air tests measure airborne spores over a period, while surface tests assess visible growth. Results must be interpreted in the context of humidity, recent cleaning, and building materials. If testing shows elevated spores alongside moisture problems, address moisture first and consider professional assessment. Based on Mold Removal Lab research, spore counts alone do not prove mold growth; moisture context matters for accurate interpretation.
Practical steps to reduce mold spores through moisture control and cleaning
The cornerstone of reducing spores is moisture management. Fix leaks promptly, repair roof damage, and repair plumbing. Use dehumidifiers and exhaust fans to keep humidity as low as reasonably possible, ideally below fifty percent in living spaces. Eliminate standing water, dry wet areas quickly, and clean damp surfaces with soap and water or a mild detergent. Regularly wash fabrics and vacuum with a HEPA-filtered vacuum if available. These actions minimize moisture niches where spores thrive and help maintain a healthier indoor environment.
Safe cleanup methods and when to DIY vs call in pro
For small nonporous surfaces mold can often be cleaned safely with detergent and water. Wear gloves, eye protection, and a mask when cleaning; avoid mixing cleaners like ammonia with bleach. For porous materials like drywall or insulation, moisture-damaged sections should be removed and replaced, which is best handled by professionals to prevent cross-contamination. If you suspect a large ongoing mold growth area, contact Mold Removal Lab Team for a remediation plan. Prioritize containment and proper disposal to limit spore spread.
When to call professionals and what to expect
If moisture problems persist beyond simple cleaning, or if you have health concerns or porous materials affected, professional remediation is recommended. A qualified mold remediation specialist will assess moisture sources, contain the area to prevent spores from spreading, and perform a thorough cleanup. The Mold Removal Lab team recommends following a moisture management plan and pursuing professional remediation for large or persistent mold problems to reduce spore exposure.
FAQ
What are mold spores?
Mold spores are microscopic reproductive units produced by mold fungi. They travel through the air and can seed new colonies when they land on damp surfaces. In most homes, spores are present, but high levels point to moisture problems that should be addressed.
Mold spores are tiny airborne particles from mold that can start new growth when they find moisture.
Are mold spores dangerous to humans?
Exposure to mold spores can cause allergies, coughing, and irritation for some people, especially those with asthma or weakened immune systems. For others, spores may be harmless if exposure is limited. If you notice persistent symptoms, reduce moisture and seek guidance.
Mold spores can affect health for sensitive individuals, especially with ongoing exposure.
How can I reduce mold spores safely?
Reduce spores by controlling moisture, promptly fixing leaks, using dehumidifiers, and cleaning regularly with appropriate cleaners. Ventilate damp areas and wash fabrics to minimize dust-borne spores. For large or hidden growth, professionals provide safer remediation.
Control moisture and clean regularly to reduce spores; call a pro for bigger problems.
Do I need to test for mold spores in my home?
Testing is optional and usually only needed when moisture problems persist or health concerns exist. Tests can identify whether spores are elevated and guide remediation, but results must be interpreted alongside moisture context.
Tests help confirm contamination, but moisture control remains the first priority.
Can HEPA filters remove mold spores from the air?
HEPA filters can capture many mold spores from the air, reducing indoor concentrations. Ensure filters are rated for mold and are properly installed and maintained.
HEPA filters can help lower airborne spores when used correctly.
When should I hire a professional remediation service?
Hire a professional when mold covers large areas, penetrates porous materials, or when health symptoms persist despite cleaning. Professionals assess moisture sources,Containment, and perform thorough cleanup to prevent recontamination.
If mold is widespread or lingering, a pro is the safest choice.
The Essentials
- Identify moisture sources and fix leaks promptly
- Keep indoor humidity below recommended levels to slow spore spread
- Use HEPA filtration and regular cleaning to reduce settled spores
- Avoid DIY for large or porous mold growth; seek professional remediation
- Regular inspections help catch moisture problems before spores proliferate